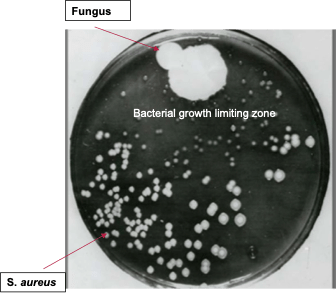

It’s been more than two years since I wrote anything for this blog. Why, you ask? It’s for the simple reason that I have been unsuccessful at finding a work- life balance. In fact, I started writing this in August this year, and four months later, I’m still writing! I’m not the first scientist to experience no work- life balance and I certainly won’t be the last, but my inadvertent descent into workaholism made me rather reflective on my role as a postdoctoral scientist and why so many postdocs over the world are choosing to leave their roles, or academia entirely.
For those of you who are unfamiliar with the term postdoc, it stands for postdoctoral researcher, or an early career scientist post their PhD. It is a complicated job, as people in this position tend to be highly skilled and trained, but at least within the university/academic system, are not considered full time employees. This is despite the fact that research output from labs is driven by postdoc labour. Contracts also tend to be short, leading to uncertainty and a constant sense of destabilisation and anxiety about job security. On the flip side, a postdoc is a fantastic opportunity to conduct independent research, travel to and live in other countries for work, and meet incredibly interesting people from all over the world. It is a transitionary career step, either towards a tenured position in a university (highly unlikely), or towards what is known in derogatory terms as an ‘alternative career’. In recent years, I have noticed a lot of colleagues choose the ‘alternative’ career path, after a few years as a postdoc. I have never seen them happier.
Recent articles published in Science and Nature reveal the chronicity of the great postdoc exodus from academia. These studies were conducted after the pandemic, and they report that most postdocs felt that they were insufficiently supported during the pandemic and experienced severe stress and mental distress about the state of their research. After the job market rebounded, naturally, many chose to move away from academia towards greener pastures in the industry or beyond. Conversely, this postdoc exodus adversely affected young group leaders who depend on postdocs for their research to move forward. Several group leaders reported an insufficiency of applicants, leaving funds to lie around and project to lag deadlines.
I cannot speak for why other postdocs make their life choices, but from a personal standpoint, the lack of a work- life balance and poor job security are the main reasons I am actively looking to move away from this career path. I have the privilege of working at a research institute that conducts cutting edge research, has pharma funding and has some of the nicest people I have ever met working there. However, despite these positives, the pressure of completing complex, sometimes impossible experiments within tight industry driven timelines can be overwhelming. The nature of the projects demands long working hours well outside those contractually obligated and I often come home without the bandwidth to do much else other than collapse on my sofa and watch trash TV to unwind. While the work is intellectually stimulating, the obvious drawbacks take a physical and mental toll over time. It doesn’t help that the lack of non- working time does not leave room for activities that help me unwind, only fuelling the stress and frustration with the job.
After lots of introspection, several meltdowns, and HOURS of therapy, I started making changes to my life to improve the situation. I now make sure to leave the lab after the requisite 8 hours unless there is something urgent to be completed. I don’t try to read that extra paper, or squeeze in just one more tiny task. I also set boundaries with my colleagues, as due to my seniority in the team, I often found myself spending too much time helping more junior members, rather than completing my often overflowing to- do lists. I signed up for music lessons at least once a week, so that every Friday and maybe the odd Wednesday, I must leave work at a certain time. The downside of making these changes? My productivity as a postdoc has dropped, reinforcing the notion that to be productive as a postdoc, one must sacrifice life outside of work. I however, no longer care, and am actively working on my transferable skills and gaining essential skills to move into the career of my choice. I will definitely write about it when that happens, hopefully sooner rather than later!